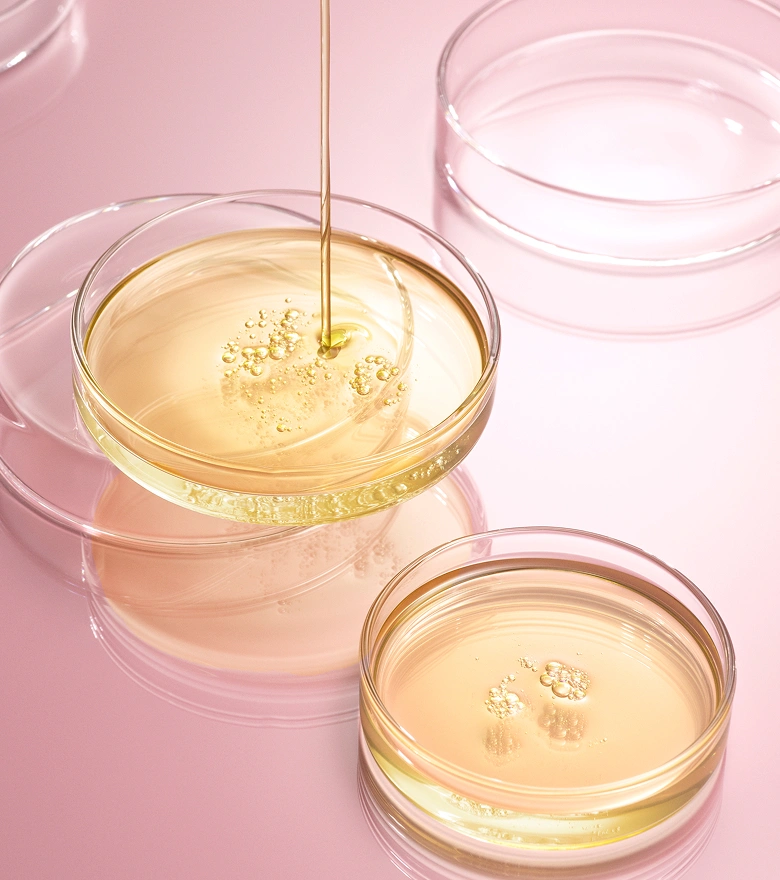

- HOME HOME
- CONCEPT CONCEPT
- METHOD METHOD
-
PRODUCTS
-
ONLINE STORE

















「PPT系洗浄成分※2」を贅沢に配合。
洗いながら髪に潤いを与え、さらに
「毛髪構成成分※3」で内側まで集中補修することで、
まるで生まれたてのような髪へ導きます。

※1 KERAFORCE処方により毛髪を洗浄し補修することで、髪の質感を向上させること ※2 ココイル加水分解ケラチンK(羊毛)、ラウロイル加水分解シルクNa(洗浄成分) ※3 毛髪構成成分由来の補修成分として KERAFORCE NO.01配合「タンパク質加水分解物(PPT)洗浄成分」のココイル加水分解ケラチンK(羊毛)(洗浄成分)、KERAFORCE NO.03配合「ナノCMCセラミド」のセラミドNG・セラミドNP・セラミドAP・コレステロール(羊毛)、KERAFORCE NO.04配合「アミノコンプレックス」のプロリン・トレオニン・アルギニン・リシン・アラニン・グルタミン酸・グリシン・セリン、KERAFORCE NO.05配合「18-MEA」(イソアルキル(C10-40)アミドプロピルエチルジモニウムエトサルフェート)、KERAFORCE NO.05配合「中分子カシミヤケラチンPPT」(加水分解ケラチン(カシミヤヤギ))、KERAFORCE NO.05 & 08配合「高分子ケラチンPPT」(加水分解ケラチン(羊毛))、KERAFORCE NO.08配合「カチオン化ケラチンPPT」(ヒドロキシプロピルトリモニウム加水分解ケラチン(羊毛))、KERAFORCE NO.09配合「シリル化シルクPPT」((ジヒドロキシメチルシリルプロポキシ)ヒドロキシプロピル加水分解シルク)、KERAFORCE NO.09配合「シリル化ケラチンPPT」((ジヒドロキシメチルシリルプロポキシ)ヒドロキシプロピル加水分解ケラチン(羊毛))(すべて毛髪補修成分)